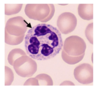
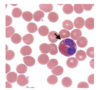
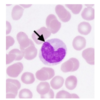
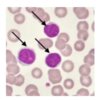
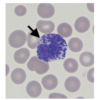

The endocrine gland that is nicknamed the “master gland”
pituitary, but really should be hypothalamus because it controls pituitary
The primary reproductive structure in the female
ovary
The mesentery that divides the liver into left and right lobes is the
falciform ligament
The finger-like processes at the ovary end of the uterine tube
fimbriae
The opening onto the interior of the kidney (allows blood vessels and other structures to enter and exit the kidney)
hilum / hilus
What are the clusters of lymph nodes in the ileum called
peyer’s patches
The rhythmic contractions of the muscularis externa that propel “food” along the digestive tract are called
peristalsis
In which specific region of the digestive system does the majority of chemical digestion occur
small intestine - most in duodenum (90%), some in jejunum
The highly twisted portion of the nephron that originates from the renal corpuscle and is the site where the greatest proportion of reabsorption occurs is the
proximal convoluted tubule
The part of the pituitary gland that is made from neural tissue
posterior pituitary
The structure formed by the ductus deferens, testicular blood vessels, nerves and muscles is the
spermatic cord
The portion of the adrenal gland that is derived from nervous tissue and is under the direct control of (is actually part of) the sympathetic autonomic division of the nervous system is the
adrenal medulla
The chemicals that are secreted by endocrine glands are called
hormones
Both the urinary bladder and the stomach have rugae.
True
The pyramids and renal columns are part of the medulla of the kidney.
True
The pyloric sphincter is located at the junction of the ileum and the large intestine.
False - between stomach and duodenum
The majority of chemical digestion (breaking of chemical bonds) occurs in the duodenum.
True
The penis can be accurately described as the ‘primary’ reproductive structure in the male.
False - testis
Blood flows towards the renal corpuscle in this specific blood vessel.
afferent arteriole
Which of the following is/are functions of the ‘primary’ reproductive structures?
production of gametes
production of sex hormones
The cell type in the testis that produces testosterone is the:
Leydig cell
The tube that drains urine from the kidney to the bladder:
ureter
Sperm are produced in microscopic tubules in the Testis. The tubules are called:
seminiferous tubules
The kidneys are located behind the peritoneal membrane, this position is described as:
retropertoneal